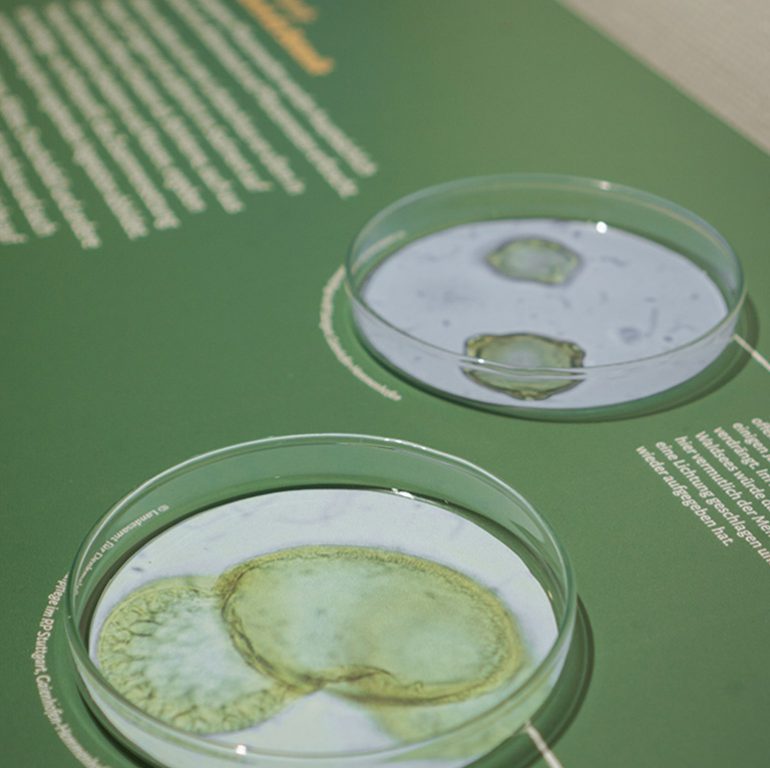
bopfingen22

Neukonzeption des archäologischen Museums als Leuchtturmprojekt der Kelteninitiative Baden-Württemberg.
| Fakten |
Ort | Ehem. Seelhaus, Bopfingen
Eröffnung | Oktober 2025
Typ | Dauerausstellung
Besonderheit | Denkmalgeschützt, diverse Medienstationen, Museum an drei Standorten
| Leistungen |
Szenografie
Architektur
Mediengestaltung
Grafische Gestaltung
Begleitmaterialien
Illustration
| Die Idee |
Das Ipf-Museum in Bopfingen sollte, als Teil des Keltenland Baden-Württemberg, die Geschichte der Kelten am Ipf sichtbar und erlebbar machen. Das Museum selbst dient hierbei als Informationsspeicher in dessen Zentrum der Ipf steht.
Ziel war es, mit dem Museum ein überregionales Kulturziel der Kelteninitiative des Landes zu schaffen.
| Besondere Herausforderungen |
Der historische Fachwerkbau setzt Grenzen für Einbauten und Technik. Gleichzeitig galt es, Inhalte sowohl wissenschaftlich fundiert, als auch für verschiedene Zielgruppen zu präsentieren. Im Fokus stand dabei eine vielfältige Vermittlung auf analoger und digitaler Ebene, die sich nahtlos in die Räume integriert, ohne deren eindrucksvolle Wirkung zu überlagern.
| Die Ausstellung |
Assoziativ greift der Einstiegsbereich die bereits erforschten und bekannten Aspekte, aber auch die ungeklärten Fragen und offenen Stellen mit Informationssplittern auf. Diese öffnen sich auf großer, weißer Fläche und lassen dabei Raum für weitere Erkenntnisse.
Zentrale Themen wie die Alltagskultur, Mode, Religion oder Bestattung werden auf modernen Ausstellungselementen lebendig. Die vielfältigen analogen und multimedialen Aktiveinheiten laden die Besuchenden buchstäblich zum Erforschen und Entdecken der Keltenwelt ein.
Räumlich und gestalterisch entsteht durch das Zusammenspiel aus zeitgemäßer Ausstellungsarchitektur und dem historischen Fachwerkhaus ein besonderes Spannungsfeld.
Ergänzt wird die Ausstellung im Museum durch das Freilichtmuseum am Fuße des Ipf und einem daran anschließenden digitalen Rundgang.